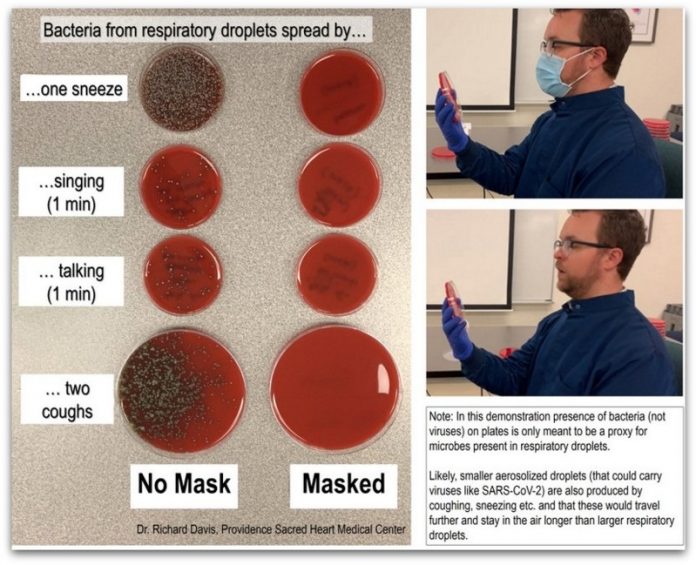

Сè уште има оние кои не се убедени дека носењето маска штити од вируси, па научниците решија да им илустрираат преку едноставен експеримент колку навистина е ефективна маската.
Д-р Рич Дејвис ги покажа резултатите од двата експеримента на Твитер, кои добро покажуваат како маската ги блокира капките од устата и грлото кога киваме, пееме, зборуваме, кашламе.
Токму тоа го стори Дејвис по тој редослед – прво без маска, а потоа и со маска. Се покажа дека бактериите најмногу се шират кога киваме или кашламе, помалку кога пееме или разговараме, но маската успеа да ги запре целосно во секој од случаите.
Во вториот тест, Дејвис се занимаваше и со далечина. Кашлаше на одредено растојание, прво со маска, а потоа и без неа, и набљудуваше во кој лабораториски сад ќе се развиваат бактериите.
What does a mask do? Blocks respiratory droplets coming from your mouth and throat.
Two simple demos:
First, I sneezed, sang, talked & coughed toward an agar culture plate with or without a mask. Bacteria colonies show where droplets landed. A mask blocks virtually all of them. pic.twitter.com/ETUD9DFmgU
— Rich Davis, PhD, D(ABMM), MLS ??? (@richdavisphd) June 26, 2020
Се покажа дека без маска, ако некое лице кашла (дури и само 15 секунди), вие сте безбедни оддалечени само околу два метра, додека со маска нема опасност дури и на кратко растојание.
„Свесен сум дека овој пример не го покажува ширењето на вирусот, но колониите на нормални бактерии од устата и грлото покажуваат големи респираторни капки, како што се оние за кои се верува дека најмногу ги шири ковид 19, и како маската ги блокира“, рече Рич Дејвис, чиј експеримент привлече големо внимание токму затоа што едноставно укажува на важноста на носење заштитна маска во актуелната состојба.
Exclusive: How effective is a mask? We headed to @providence_phc's lab with @richdavisphd to find out. I did the following with and without a mask: talk, sing, cough, and sneeze. We just got the results today. Full story airs tonight at 6 on @KHQLocalNews. pic.twitter.com/I32VhXXEfF
— Kevin Kim (@NewsWithKevin) June 26, 2020